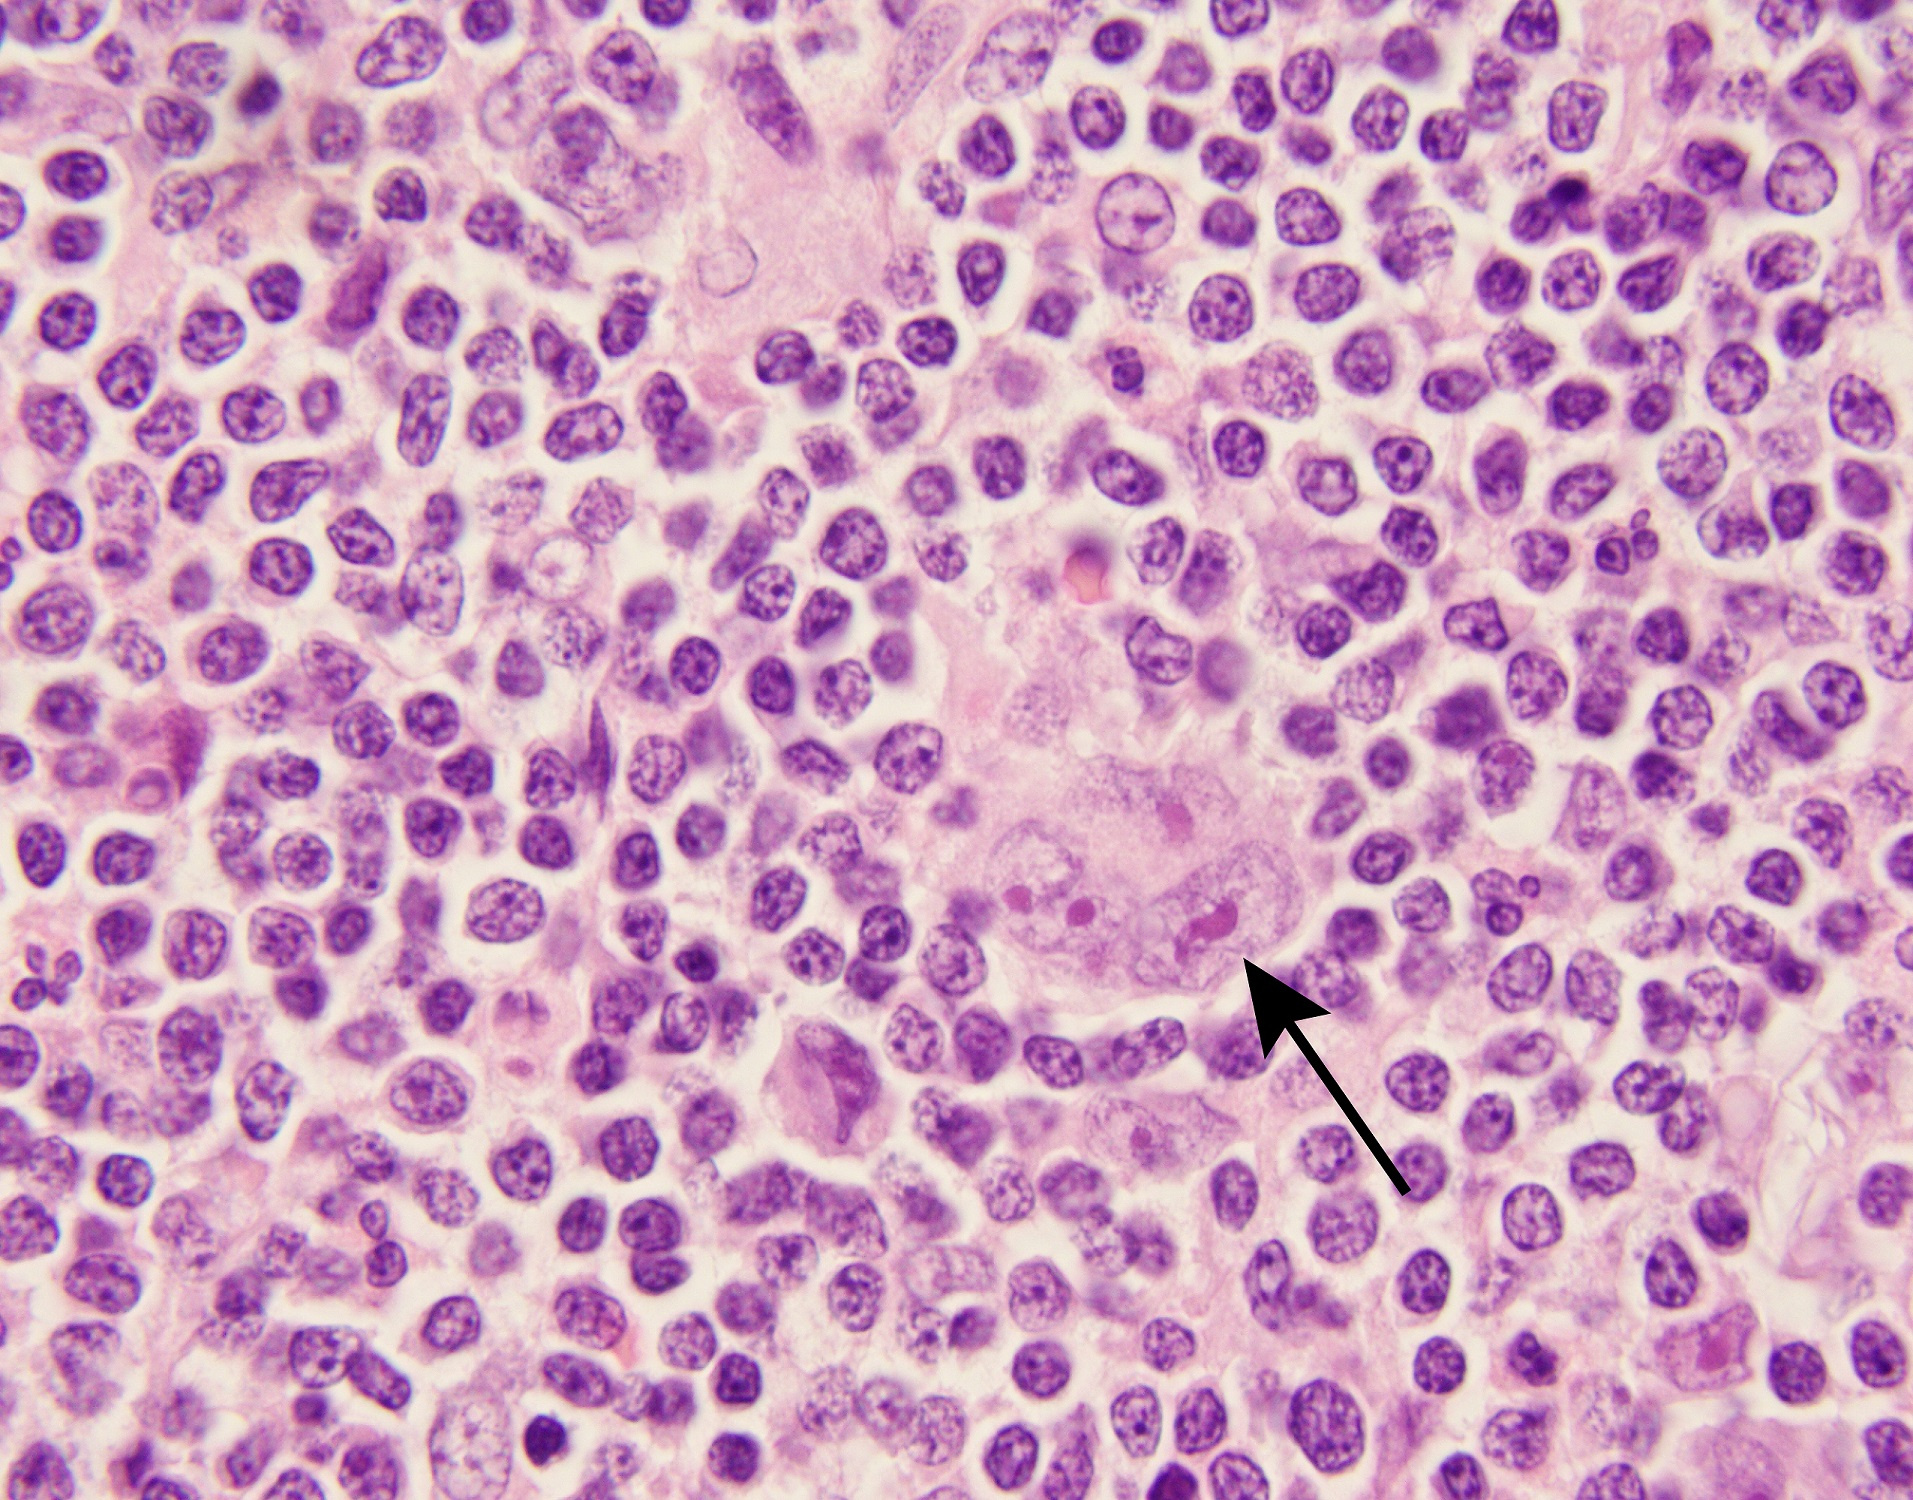

A peripheral immune signature of responsiveness to PD-1 blockade in patients with classical Hodgkin lymphoma
Published in Cancer

Classical Hodgkin lymphomas (cHLs) are unusual B-cell tumors in which rare malignant Hodgkin Reed Sternberg (HRS) cells are embedded within an extensive, but ineffective, inflammatory/immune cell infiltrate (Figure 1). In earlier studies, we found that cHLs had near-uniform copy gain of 9p24.1/CD274(PD-L1)/PDCD1LG2(PD-L2) – a genetic basis for PD-1 mediated immune evasion1. The findings were rapidly translated into clinical trials in which patients with cHL had the highest reported response rates to PD-1 blockade2-4. Despite this clinical success, the mechanism of action of PD-1 blockade in cHL remained undefined.
In certain solid tumors, PD-1 blockade is reported to increase the activity of CD8+ cytotoxic T-cells which recognize tumor antigens via MHC class I. However, malignant HRS cells are largely MHC class I-negative, as a consequence of genetic perturbations of B2M or MHC class I gene loci5,6.
In clinical trials of PD-1 blockade, we previously found that responses were significantly associated with HRS cell expression of MHC class II, but not of MHC class I, suggesting a potential role for CD4+ T-cells5. Additionally, the cHL immune cell infiltrate was significantly enriched for CD4+ T-cells, including in the immediate vicinity of HRS cells7,8.
In the current study (click here), our collaborative group used the complementary approaches of T-cell receptor (TCR) sequencing and cytometry by time-of-flight (CyTOF) analyses to characterize the peripheral immune signature of patients with cHL who received anti-PD-1 therapy (Figure 2).
PD-1 blockade was most effective in patients with a diverse baseline TCR repertoire and an associated expansion of singleton, rather than non-singleton clones, during therapy. CD4+, but not CD8+, TCR diversity significantly increased on treatment, most notably in patients who obtained complete responses to PD-1 blockade. In addition, responding patients had increased numbers of circulating activated natural killer cells and a recently identified granzyme B-positive subset. Our studies revealed the roles of newly expanded, clonally diverse, CD4+ T-cells and additional innate effectors in the response to PD-1 blockade in cHL.

References
- Roemer MG, Advani RH, Ligon AH, et al. PD-L1 and PD-L2 Genetic Alterations Define Classical Hodgkin Lymphoma and Predict Outcome. J Clin Oncol. 2016;34(23):2690-2697.
- Ansell SM, Lesokhin AM, Borrello I, et al. PD-1 blockade with nivolumab in relapsed or refractory Hodgkin's lymphoma. N Engl J Med. 2015;372(4):311-319.
- Armand P, Engert A, Younes A, et al. Nivolumab for Relapsed/Refractory Classic Hodgkin Lymphoma After Failure of Autologous Hematopoietic Cell Transplantation: Extended Follow-Up of the Multicohort Single-Arm Phase II CheckMate 205 Trial. J Clin Oncol. 2018;36(14):1428-1439.
- Chen R, Zinzani PL, Fanale MA, et al. Phase II Study of the Efficacy and Safety of Pembrolizumab for Relapsed/Refractory Classic Hodgkin Lymphoma. J Clin Oncol. 2017;35(19):2125-2132.
- Roemer MGM, Redd RA, Cader FZ, et al. Major Histocompatibility Complex Class II and Programmed Death Ligand 1 Expression Predict Outcome After Programmed Death 1 Blockade in Classic Hodgkin Lymphoma. J Clin Oncol. 2018;36(10):942-950.
- Wienand K, Chapuy B, Stewart C, et al. Genomic analyses of flow-sorted Hodgkin Reed-Sternberg cells reveal complementary mechanisms of immune evasion. Blood Adv. 2019;3(23):4065-4080.
- Cader FZ, Schackmann RCJ, Hu X, et al. Mass cytometry of Hodgkin lymphoma reveals a CD4(+) regulatory T-cell-rich and exhausted T-effector microenvironment. Blood. 2018;132(8):825-836.
- Carey CD, Gusenleitner D, Lipschitz M, et al. Topological analysis reveals a PD-L1-associated microenvironmental niche for Reed-Sternberg cells in Hodgkin lymphoma. Blood. 2017;130(22):2420-2430.
Follow the Topic
-
Nature Medicine
This journal encompasses original research ranging from new concepts in human biology and disease pathogenesis to new therapeutic modalities and drug development, to all phases of clinical work, as well as innovative technologies aimed at improving human health.
Related Collections
With Collections, you can get published faster and increase your visibility.
Clinical Research in Respiratory Medicine
Publishing Model: Hybrid
Deadline: Feb 18, 2027
Cancer Prevention and Control
Publishing Model: Hybrid
Deadline: Feb 19, 2027





Please sign in or register for FREE
If you are a registered user on Research Communities by Springer Nature, please sign in